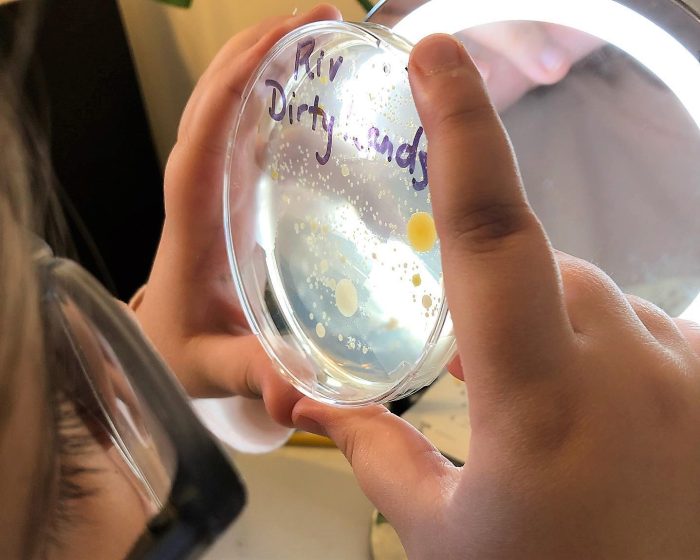
homeschool science grow bacteria

There’s nothing quite like homeschool science experiments to bring the entire family together. Maybe your child is a born academic, or maybe they’re the type of kid who resists more traditional education. Either way, it’s a rare child who can resist an educational activity disguised as a fun homeschool science experiment!
So gather the family and collect a few supplies from around the house. Get ready to teach your kids through some fun science projects. And as your kids learn more about the world God created around them, maybe you’ll learn a thing or two as well!

31 Fun Homeschool Science Experiments
If you’re looking for a collection of fun science experiments using common household items, look no further! While science experiments of any kind are a blast, they’re especially impactful when you pair them with incredible living books, hands-on learning activities, and science experiment videos about the subject as well. We’ve divided these experiments into several groups:
- Easy science experiments for kids in the seven-and-under crowd (but of course, they can be enjoyed by kids of all ages!)
- Biology experiments
- Chemistry experiments
- Earth science experiments
- Anatomy and physiology experiments
- Astronomy experiments
Some of these experiments, of course, could fit into several categories. So be sure to bookmark this page, and you can keep coming back for more fun homeschool activities your kids will love!
Simple Experiments for the Younger Crowd
Young children are insatiable learners by nature. They crave learning and activities, particularly if they have older siblings they admire who are doing more “grown up” schooling. Here are just a few ideas for activities to capture their attention while also teaching them a thing or two about the world.
1. Exploring Colors (and Chemistry) With Baking Soda and Vinegar
All you need for this simple experiment is:
- Baking soda
- Foil tray/dish
- Vinegar
- Liquid food coloring
- Pipette or dropper
First, fill the foil tray with a layer of baking soda. You want the bottom of the tray to be completely covered.
Pour vinegar into individual cups OR an empty ice cub tray. Add your selected food coloring to each one.
Finally, let your child use the dropper to extract the colored vinegar and dispense it into the tray. They’ll be amazed at both the chemical reaction and the bright colors!
2. Make a Rubber Egg

Have you ever met a young child who doesn’t like to pick up an egg and casually just smash it on the ground? With this fun experiment, your child can make a rubber egg! All you’ll need is one egg and some vinegar!
3. Changing the Color of Flowers
Another affordable option that is just SO easy for younger children:
- White flowers (carnations are best and often the cheapest)
- Food coloring
Add water to as many cups as you have flowers! Then, stir 10-15 drops of food coloring into each cup.
Trim the stem of each flower and then put one flower in each cup. Over the next few hours, your kiddo will observe the flowers changing into the color of the food coloring the stem is resting in!
*Note: If you don’t want to buy flowers, this can be done with stalks of celery! Just make sure each stalk has leaves on one end, and place the stalk in the water bottom-side down.
4. Candy Corn Experiment
Looking to use up all that extra candy corn from Halloween? Your child can predict and observe how candy corn reacts to water, heat, and cold.
Fill a glass with water and drop a few pieces of candy corn into the glass. Ask your child what they think will happen to the candy and then allow them to observe what actually happens. They can even write or draw what they see in the glass.
In a second empty glass, add a few pieces of candy corn and put the glass in the microwave. Heat for 45 seconds and let your child watch what happens to the candy corn as it heats. In a similar fashion to the first part of the experiment, document, and draw!
For the final portion of this experiment, take a third empty glass and add candy corn to it. Put the glass in the freezer and ask your child what they think the candy will look like in a few hours. Later in the day, take the glass out of the freezer and let your child see for themselves!
5. Plant an Herb Garden

I love this science activity because you as the teacher can benefit from the outcome of the experiment! Seeds are cheap to buy, and you can grab dirt right from your backyard. Poke a few holes in the bottom of a disposable cup and help your child plant herb seeds. Basil is my personal favorite because it is fragrant and easy to grow! As the seedling sprouts and grows, your child can draw what they see each day.
6. Homemade Lava Lamp
*Note: this experiment is best for kids who are old enough to know NOT to put random objects in their mouths.
For this chemistry-style experiment, you will need:
- Vegetable oil
- Food coloring
- Alka Seltzer tablets (available at most drugstores or grocery stores!)
To start, combine one-half of a cup of water with your child’s choice of food coloring. Break an Alka Seltzer tablet into a couple of pieces. This is where you want to be careful that your child does not put the pieces in their mouth!
In a tall glass, pour three-quarters of a cup of vegetable oil. Pour in the water-food coloring mix until the glass is one to two inches from being full. No need to stir!
Add the pieces of the Alka Seltzer tablet to the cup. Watch the bubbles form!
Biology Experiments
Biology is a fascinating subject for all kids. Using the five senses to explore living things around them comes naturally to children of all ages. Here are a few easy science experiments to help your student learn about biology!
7. Green Bean Seedlings

Did you know that you can start growing green beans in a plastic bag with no dirt needed? Here’s what you’ll need and how to do it:
- Green bean seeds
- Paper towels
- Gallon-sized plastic bag
To begin, layer and wet two sheets of paper towels and squeeze the excess water out. Fold the paper towel a few times so it is a thicker layer. Lay the paper towel flat and slide it into the plastic baggie.
Place a few bean seeds on top of the wet paper towel and seal the bag. Now, watch and wait! Over the course of the next few days, you should see the seeds swell and eventually sprout!
8. Extract Your Own DNA
Using your own saliva, you can extract your DNA and even take it a step further by studying your DNA under a microscope!
9. Grow Bacteria in a Petri Dish
With the help of a petri dish and some beef bouillon, you can actually grow bacteria!
10. Sourdough Starter
“Regular” bread usually rises due to the addition of yeast. Sourdough bread, however, uses the process of fermentation to help bread rise. This creates a distinct flavor that we know as sourdough, and you and your student can make it at home! Fun experiment; tasty result!
11. Seven Easy Homeschool Biology Experiments for High School Students
Want biology experiments that are designed just for the higher grade levels? Check out these experiments that we’ve compiled!
Chemistry Experiments
Whether your child is destined to be a professional chemist or just enjoys blowing things up for fun, chemistry experiments are some of the most fun. These experiments should be approached with a dose of caution, though. Never combine any two chemicals when you don’t know the expected outcome, and be sure to dispose of your chemicals in the proper manner.
12. Slime

Slime is one of those fun homeschool ideas that kids love, but parents dread. The mess…ugh. But slime is all the rage these days; kids just LOVE it! With just a few basic ingredients, your child can make it home and learn about the science beyond the stretchy, gooey, crazy-fun mess that we call slime!
13. Invisible Ink
The “magic” of invisible ink displays the chemical process of oxidation. To create this magic, you’ll need:
- Lemon juice
- Cotton swab
- White paper
- A working lightbulb
First, add a tablespoon of lemon juice to a bowl with a few drops of water; mix.
Dip the cotton swab into the lemon-water mixture and write a message on the piece of white paper. Let the message dry completely.
Once dry, hold the paper up to the heat of the lightbulb and watch your secret message appear!
14. Colored Fire
I’ll never know why, but kids are mesmerized by fire. With this simple activity, you can change the color of fire using copper sulfate and alcohol-based fuel.
15. Rock Candy

Did you know that you can make edible crystal “rocks” with just sugar and water? Customize these edible creations with your students’ favorite colors!
16. Melting Salt With Ice
Ever wonder about the “why” behind salt trucks in winter? Create your own mini icy spot and use salt to watch the ice melt away!
Earth Science Experiments
Almost all of us can remember having a rock collection at some point in our childhoods! We were fascinated by the various colors, shapes, and textures. Weather is fascinating to children as well. And for kids who are scared of certain weather patterns, learning more about their causes has the added effect of making these storms less scary!
17. Make It Rain Indoors!
With just ice cubes, water, a plate, and a jar, you can simulate the water cycle that produces rain!
18. Rain Clouds in a Jar
This simple experiment uses shaving cream and water in a glass to simulate rain and clouds.
19. Tornado in a Jar
While you have your jar out and the weather on your mind, go ahead and try this tornado-in-a-jar experiment!
20. Chocolate Ice Wedging and Erosion Simulation
In this activity, you get to play with chocolate—but not eat it! You will simulate ice wedging using a balloon and some chocolate Magic Shell®. This science activity is actually a part of our Earth Science Explored curriculum at Journey Homeschool Academy!
*Note: Any leftover Magic Shell® can and should be eaten! Yum!
21. Chocolate Rocks
More chocolate? Yes, please! This easy and delicious science experiment will teach your homeschool student about the difference between sedimentary, igneous, and metamorphic rocks!
Anatomy and Physiology Experiments

The human body is truly incredible, and we so often take for granted just how flawlessly each of our systems works. These experiments will help your student understand his/her body better and will get down into the nitty-gritty of human anatomy and physiology.
22. Pumping Heart Model
Create a model of the human heart and watch how it works so efficiently inside each of our bodies.
23. Working Lung
Breathing seems easy, but the science behind how our lungs work is intricate and unique. Your student can build their own model of the lungs and see just how breathing works.
24. Life-Size Human Body Model
This activity combines both art and anatomy and can be done with supplies you likely already have:
- Markers, crayons, colored pencils, etc.
- A roll of easel paper
Roll out the easel paper to be slightly longer than your child’s height. You can have them lay down next to it to make sure the paper length is long enough! Cut the paper once you have the right length.
Have your student lay on their back on the paper with their hands flat on the ground and their bodies as straight as possible. Using a pencil, trace their entire silhouette onto the easel paper.
Now, your student can use their own body tracing to draw and label the systems of the body. This can include organs, nerves, bones, or whatever part of the body you’re studying at that time!
25. Marshmallow and Licorice DNA

After completing this experiment, your kids will most certainly want to eat it!
You’ll need:
- Toothpicks
- Mini marshmallows
- Red licorice
Take a piece of licorice and poke 12 toothpicks evenly into and down the side of it like the rungs of a ladder. On the open end of the toothpicks, push the mini marshmallows into the toothpick (see image below).
Complete the ladder by pushing a second piece of licorice into the open end of the toothpicks. Now, twist the structure slightly so that it makes a double helix shape that mimics a DNA model!
To add a level of complexity to this experiment for older kids, you can buy colored marshmallows and separate them into the four chemical bases of DNA: adenine, thymine, guanine, and cytosine. Kids in our elementary biology course get to learn about this topic while completing this tasty activity!
26. Blood Slime
MORE SLIME. Kids will literally never get tired of slime, so use slime to teach them about the makeup of blood! It’s the perfect sensory and learning experience.
Astronomy Experiments

Ah, the beautiful night sky! Astronomy goes beyond the earth and into the wonders of the solar system. Your student can become a mini-astronomer and gain a better understanding of planets, stars, and so much more.
27. The Eclipse Experiment
Over the course of almost an entire month, the moon goes through many phases. Sometimes, the moon covers the entire sun; this is called a solar eclipse. You can mimic these phases and an eclipse with a few basic supplies and a dark room!
28. Venus Clouds
The planet Venus has an atmosphere made up of 96% carbon dioxide. This experiment displays the properties of carbon dioxide and how it affects Venus.
29. Why is the sky blue?
Ever wondered why the sky is blue? This science activity teaches kids about color wavelengths that come from the sun. You’ll also learn about why the color of the sky changes during sunset.
30. Pumpkin Solar System
If you happen to be studying astronomy in the fall season, make pumpkins into planets! You’ll need:
- Nine pumpkins of various sizes (make sure at least one is BIG!)
- Paint
- Chalk
Pick a pumpkin to assign to each planet. The biggest pumpkin should be the sun! Let your student paint each pumpkin in a way that mimics the real planet. They can even add rings using strips of paper.
Head outside to a paved area and use chalk to draw the solar system. If space allows, draw full circles; remember, the sun is the center! Once the pumpkins have dried, place each one in its correct position in relation to the center pumpkin (the sun). You can even continue the lesson by talking about other parts of the solar system and where they are in relation to your pumpkin planets.
31. Eleven Amazing Astronomy Activities for Kids
At Journey Homeschool Academy, we LOVE astronomy! That’s why we put together an entire post full of astronomy activities for kids of all ages.

Looking for More Fun, Hands-On Homeschool Science Experiments?
Do your kids love learning through a variety of hands-on experiences? If you’re looking for a fun homeschool curriculum that includes a variety of learning experiences (including plenty of cool science experiments!), you’ll love Journey Homeschool Academy. You can view our breakthrough, online video-based science curriculum broken up by age group or by subject.
Almost every lesson contains a science experiment or activity to stimulate your kids’ imaginations, promote their thinking, and challenge their assumptions about the world. Use the button below to check out previews of each of our courses!